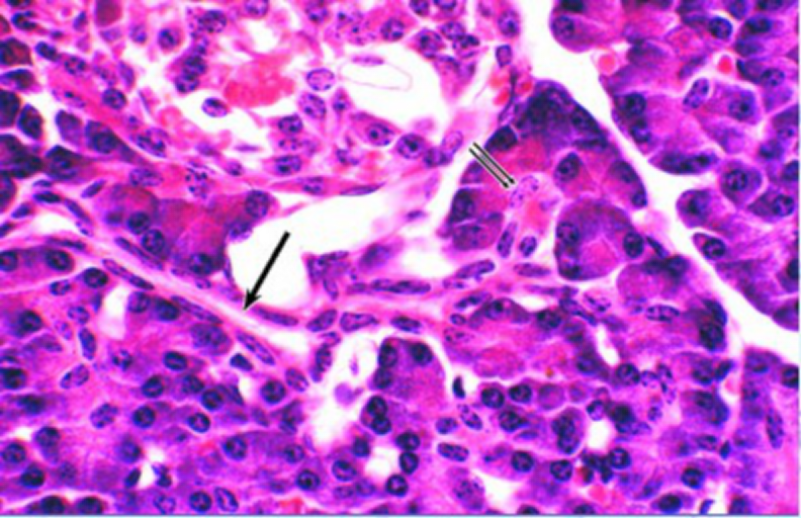

13.3.2 胰腺
-
1 内容
-
2 测验
上一节
下一节

胰腺结构模式图:



外分泌部

胰泡心细胞和闰管(人胰):
(一)腺泡:
由 pancreatic acinar cell 组成,为典型的蛋白质分泌细胞。
分泌:
1.消化酶-胰蛋白酶原、胰糜蛋白酶原、胰淀粉酶、胰脂肪酶、DNA 酶和RNA 酶等
分别消化食物中的营养成分。
2.胰蛋白酶抑制因子,防止两种蛋白酶原被激活。
3.胰腺泡细胞电镜图:
(二)导管:上皮可分泌水和 HCO3- 等多种电解质
闰管(单层扁平或单层立方上皮)
↓
小叶内导管(单层立方上皮)
↓
小叶间导管(单层柱状上皮)
↓
主导管(单层高柱状上皮)
↓
与胆总管汇合,开口于十二指肠乳头
内分泌部-胰岛pancreas islet




